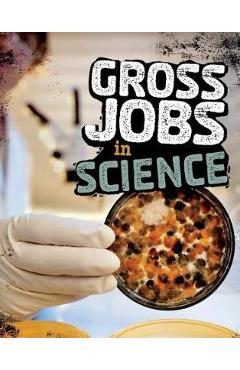
Poza produsului Gross Jobs in Science

✕


CUPON -10% Extra!
la abonare Newsletter Libris